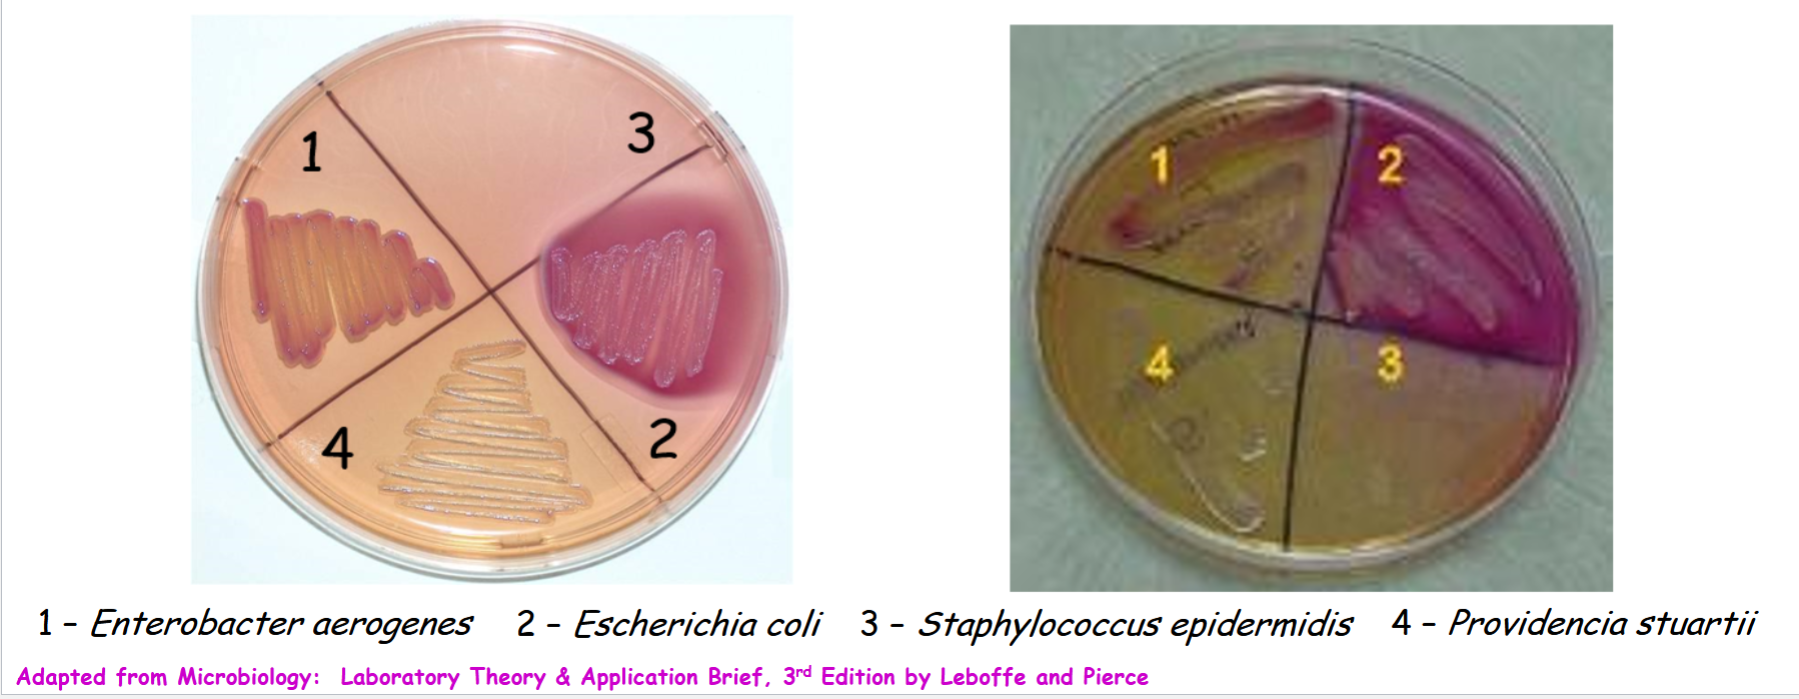
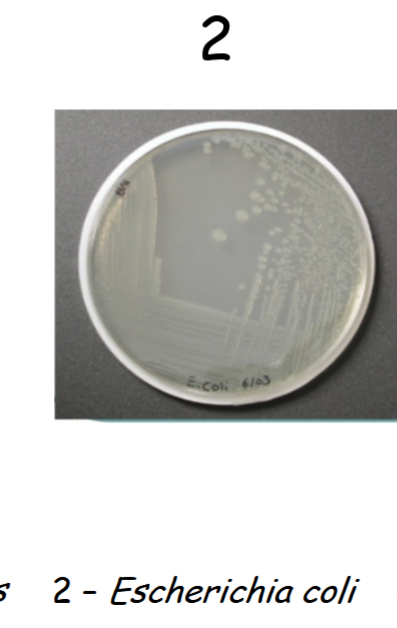
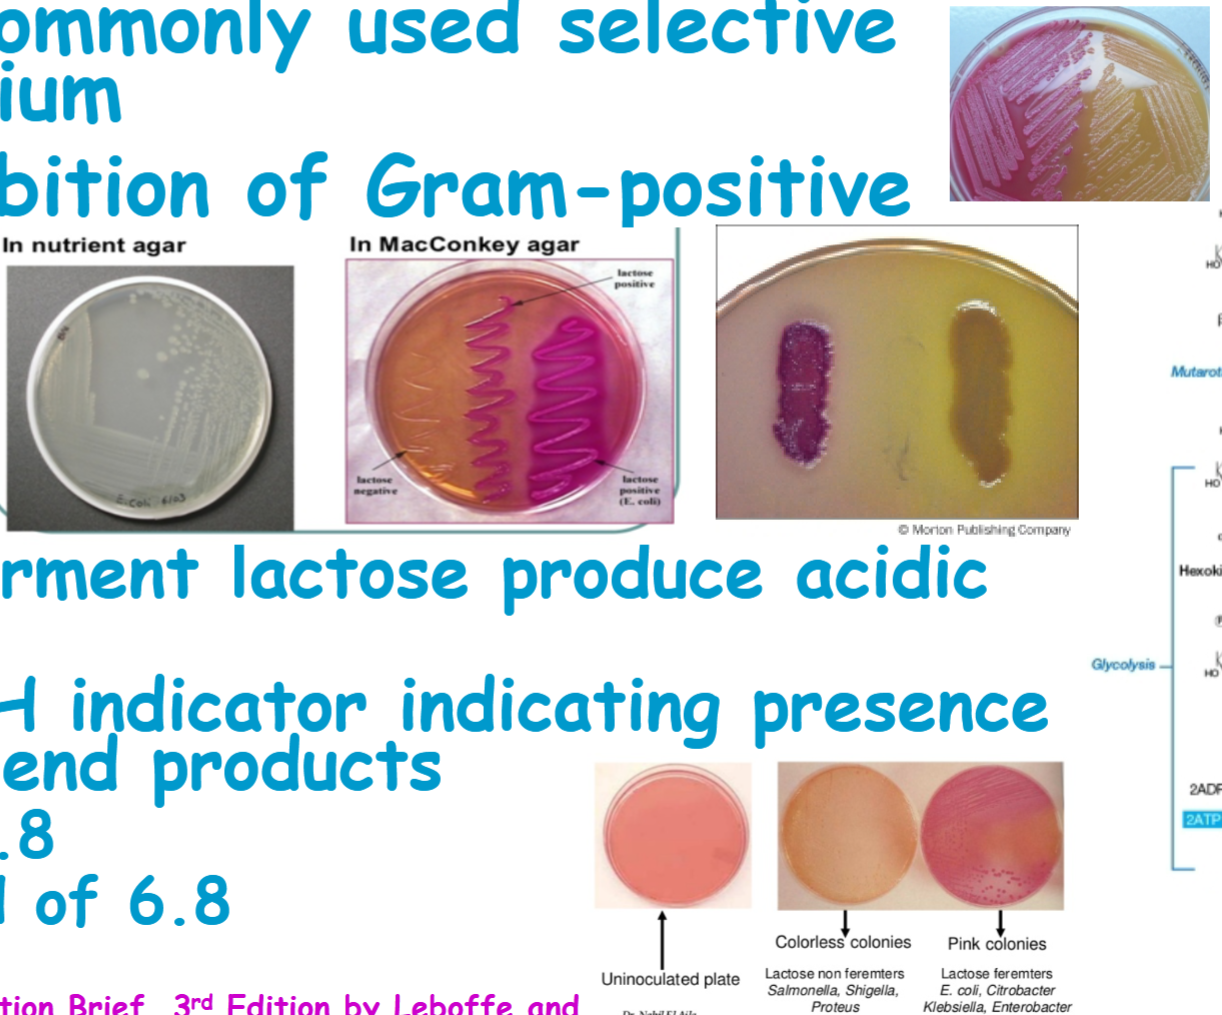
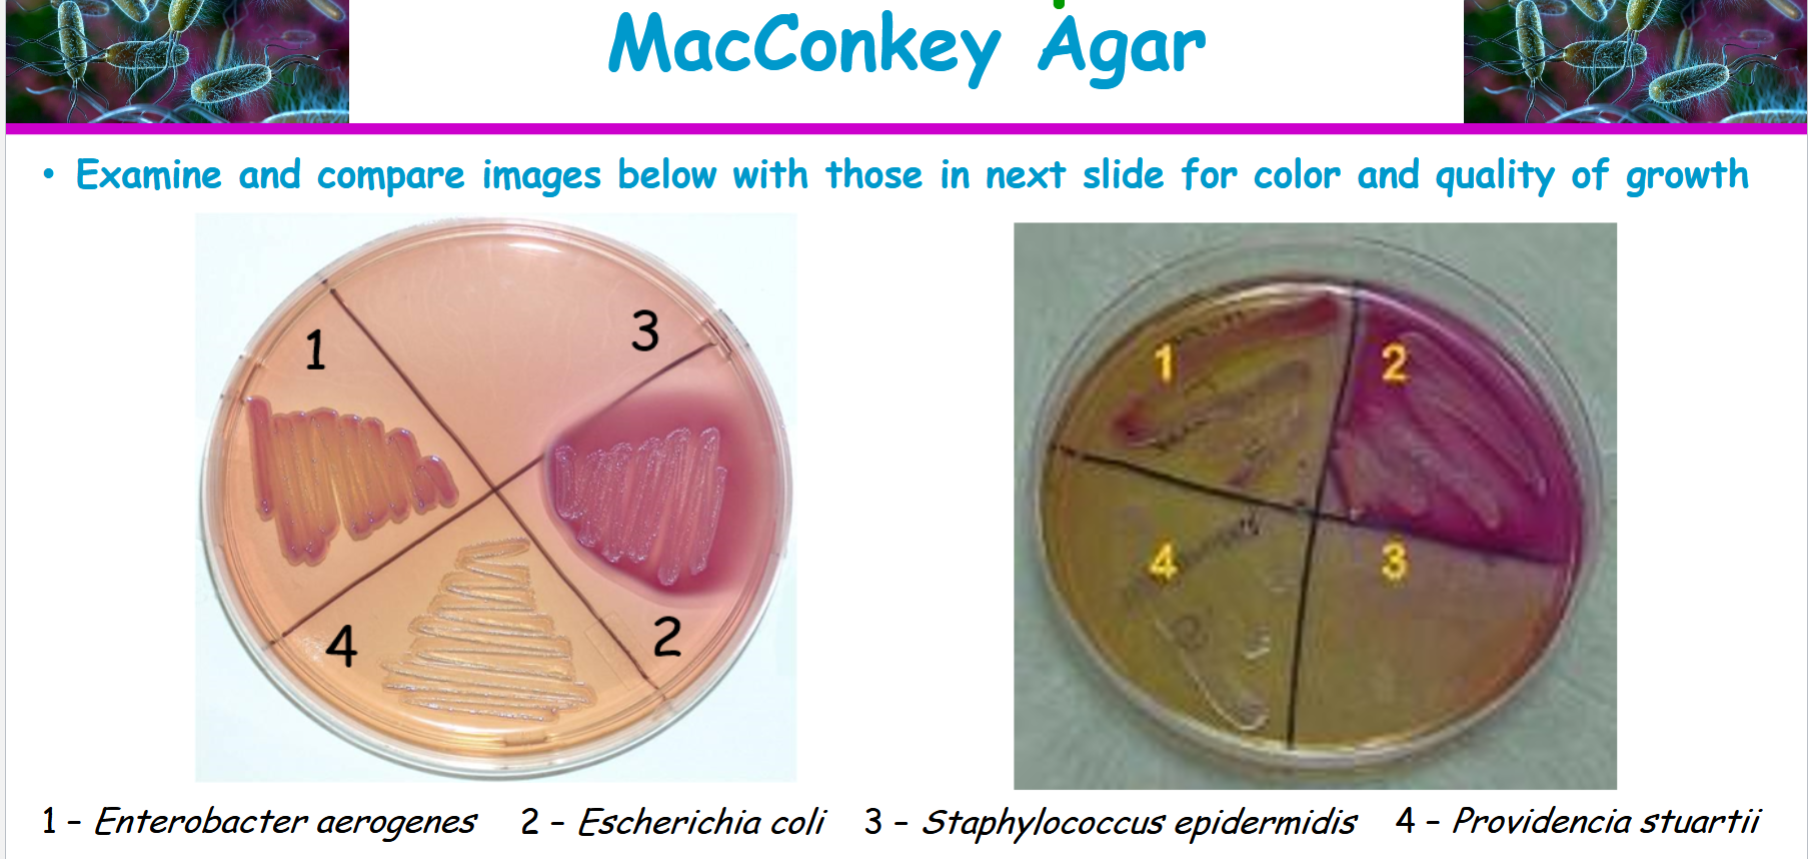
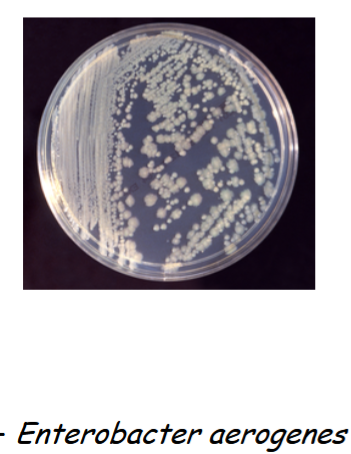
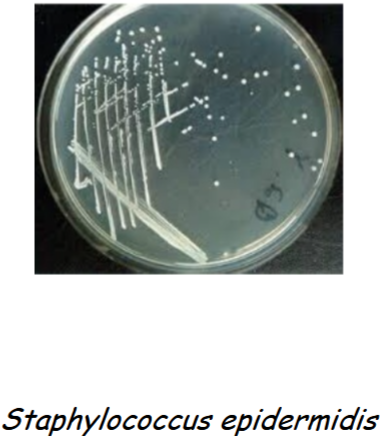
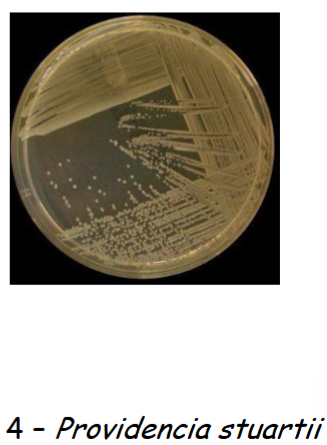

1/19
Looks like no tags are added yet.
Name | Mastery | Learn | Test | Matching | Spaced | Call with Kai |
|---|
No analytics yet
Send a link to your students to track their progress
MacConkey agar is
selective and differential
selective
due to inhibition of Gram-positive bacteria by
• Bile salts
• Crystal violet
differential
• Organisms able to ferment lactose produce acidic end products
• Neutral red dye is pH indicator indicating presence or absence of acidic end products
• Clear above pH of 6.8
• Pink to red below pH of 6.8
what MacConkey agar contains
pancreatic digest of gelatin, pancreatic digest of casein, peptic digest of animal tissue, lactose, bile salts, sodium chloride, neutral red dye, crystal violet, agar, distilled/deionized water
coliforms are
gram negative and ferment lactose
to detect coliforms, MAC agar is formulated to select for Gram-negative bacteria and then differentiates this broad grouping of microbes based on their ability to ferment lactose.
bile salts and crystal violet
in the media inhibit the growth of gram positive bacteria while allowing most gram negative bacteria to grow
selective agent
lactose
fermentable carbohydrate
It serves as the primary sugar source. The ability of gram-negative bacteria to ferment lactose is the basis of differentiation on the agar.
neutral red dye
pH indicator
This dye turns pink-red in the presence of acid. When lactose is fermented, acid is produced, causing the indicator to change color.
Peptones (e.g., peptone, proteose peptone)
nutritional base
These provide essential nutrients, including nitrogenous compounds and vitamins, required for microbial growth.
agar
solidifying agent
This polysaccharide, derived from red algae, solidifies the medium to provide a surface for bacterial growth.
sodium chloride
maintains osmotic balance
This component ensures the proper osmotic environment, preventing water from rushing into or out of the bacterial cells.
Know what bile salts and crystal violet do
act as selective agents. In the media inhibit the growth of Gram-positive bacteria while allowing most Gram-negative bacteria to grow.
what neutral red dye is and why it is added to the agar
s pH indicator indicating presence or absence of acidic end products
• Clear above pH of 6.8
• Pink to red below pH of 6.8
Know why (application) MacConkey agar is used
• Used to isolate and differentiate members of the Enterobacteriaceae based on lactose-fermenting ability
• Certain variations can also be used
Know how Escherichia coli should have grown on the MacConkey agar
pink colonies, gram negative and lactose fermenters (+)

Know what results you would expect and how to interpret them

enterobacter aerogenes
ferments lactose (+). (pink colonies), gram negative

staphylococcus epidermidis
gram positive, colorless or not present and non lactose fermenter (-)

providencia stuartii
clear, colorless and non lactose fermenter (-). Gram positive
MacConkey results and interpretations
